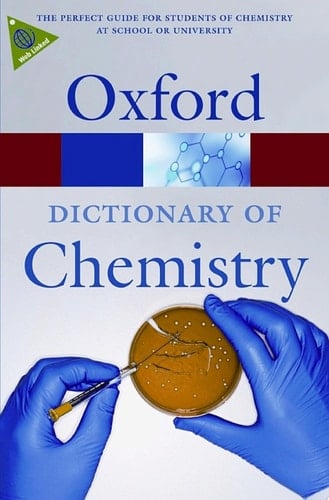
A Dictionary Of Chemistry

Fully Revised And Updated, The Sixth Edition Of This Popular Dictionary Is The Ideal Reference Resource For Students Of Chemistry, Either At School Or At University. With Over 4,700 Entires - Over 200 New To This Edition - It Covers All Aspects Of Chemistry, From Physical Chemistry To Biochemistry. The Sixth Edition Boasts Broader Coverage In Subject Areas Such As Forensics, Metallurgy, Materials Science, And Geology, Increasing The Dictionary's Appeal To Students In These Related Fields. There Are Also Biographical Entries On Key Figures, Highlighted Entries On Major Topics Such As Polymers And Crystal Defects, And A Chronology Charting The Main Discoveries In Atomic Theory, Biochemistry, Explosives, And Plastics.
Page Count:
592
Publication Date:
2008-01-01
ISBN-10:
019104492X
ISBN-13:
9780191044922
No comments yet. Be the first to share your thoughts!